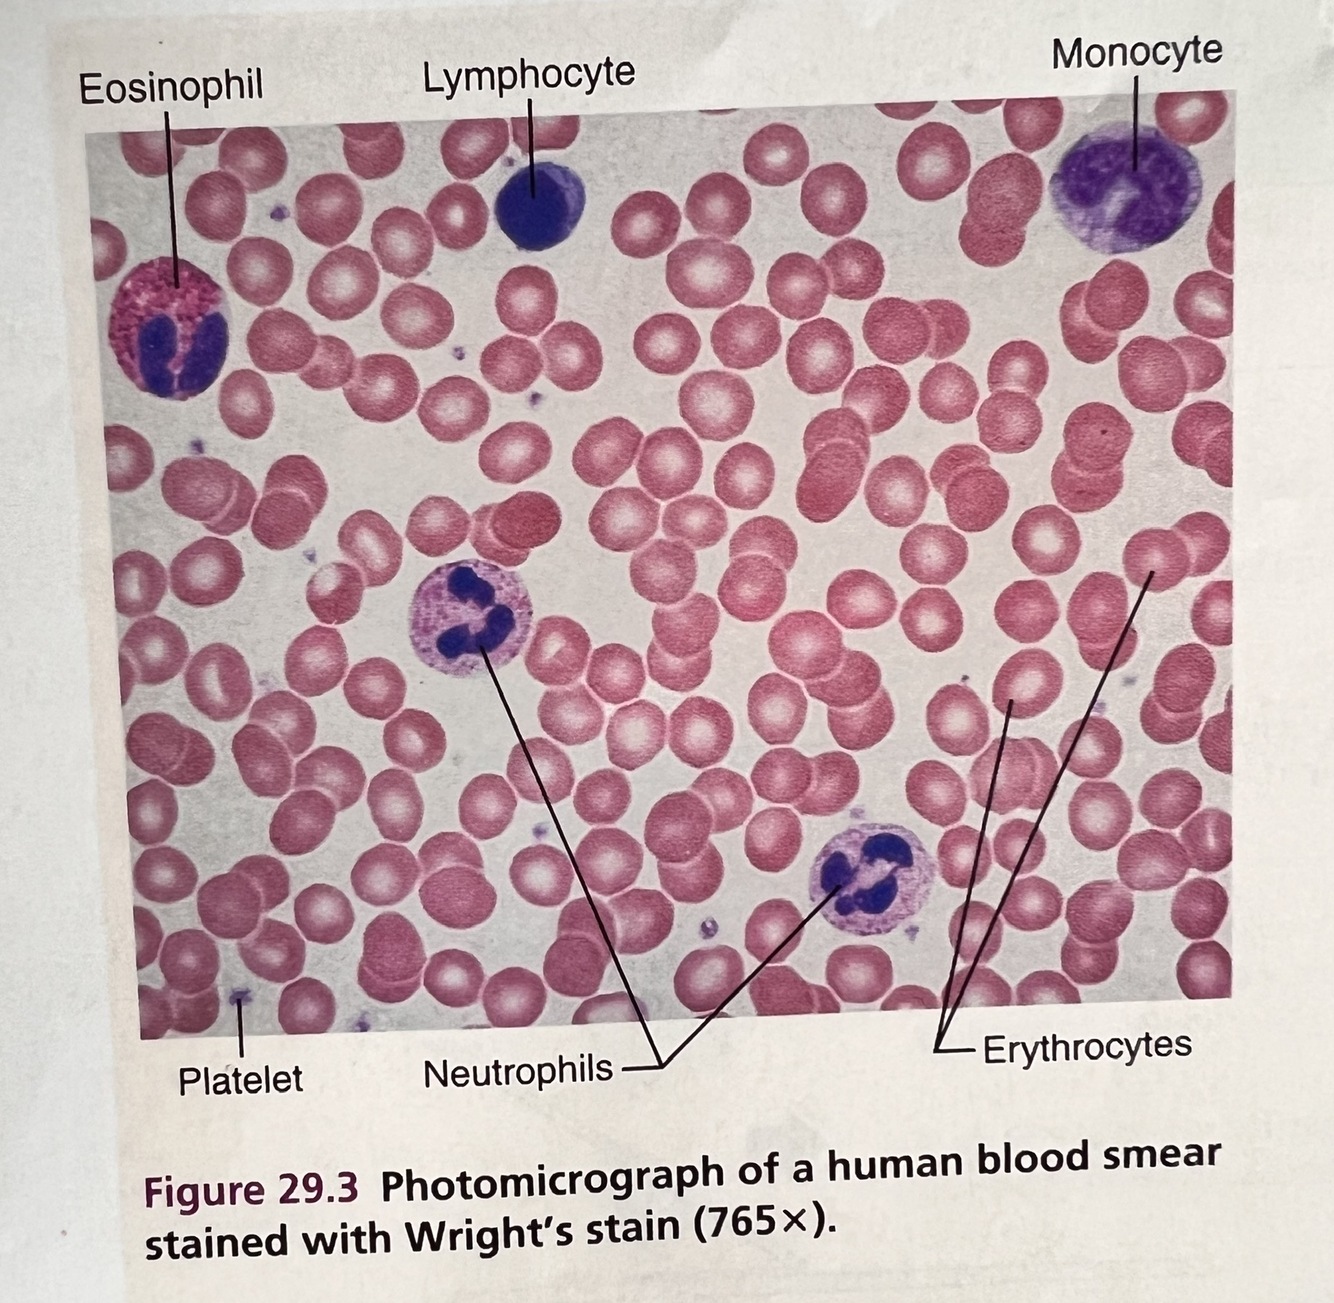

Leukocytes: Agranulocytes/Lymphocyte (description, cells/mm3 of blood, and function)

description - nucleus spherical or indented; pale blue cytoplasm; diameter 5-17 μm.
cells/mm3 of blood - 1,500-3,000; differential count: 25-45%
function - mount immune response by direct cell attack or via antibody production.

Most to least white blood cells
Never Let Monkeys Eat Bananas
Neuotrophils, Lyphocytes, Monocytes, Eoisinophils, Basophils.
Plasma %, constituent, major functions
about 55%
Water - Solvent for dissolving and carrying other substances; absorbs heat
Salts (sodium, potassium , calcium, magnesium, chloride, bicarbonate) - osmotic balance, pH buffering
Plasma proteins - albumin: osmotic balance; fibrinogen: clotting of blood; globulins: defense (antibodies and lipid transport)
Substances transported by blood - nutrients (glucose, fatty acids, amino acids, vitamins), wast products of metabolism (urea, uric acid), respiratory gases (O2, CO2), and hormones.
Formed elements %, constituent, major functions
about 45%
Erythrocytes (red blood cells) - about 4-6 mil (per mm3 of blood); functions transport oxygen and help transport carbon dioxide.
Leukocytes (white blood cells) - basophil, eosinophil, neutrophil, lymphocyte, monocyte; 4,800-10,800 (per mm3 of blood); functions are defense and imunity
Platelets - 150,000-400,000 (per mm3 of blood); function is blood clotting.
Leukocytes - Granulocytes/Neutrophil (description, cells/mm3 of blood, and function)

description - nucleus, multilobed; pale red and blue cytoplasmic granules; diameter 10-12 μm.
cells/mm3 of blood - 3,00-7,000 differential count: 50-70%
function - phagocytize pathogens or debris

Leukocytes: Monocyte (description, cells/mm3 of blood, and function)
description - Nucleus U- or kidney-shaped; gray-blue cytoplasm; diameter 14-24 μm.
cells/mm3 of blood - 100-700; differential count: 3-8%
function - in tissue, develop into macrophages that phagocytize pathogens or debris

Leukocytes: Eosinophil (description, cells/mm3 of blood, and function)

description - Nucleus bilobed; red cytoplamsic granules; diameter 10-14 μm.
cells/mm3 of blood - 100-400; differential count: 2-4%
function - kill parasitic worms; slightly phagocytic, complex role in allergy and asthma



blood types
A, B, AB, O and each can have Rh making them Rh positive or if they do not have Rh they are Rh negative.
A blood type has A antigens and anti-B antibodies. When tested it can agglutinates with anti-A serum.
B blood type has B antigens and anti-A antibodies. When tested it can agglutinates with anti-B serum
AB blood type has A and B antigens and no antibodies for against A or B. When tested it can agglutinates with anti-A and anti-B serum.
O has no antigens and has both anti-A and anti-B antibodies. When tested it does not agglutinates with either anti-A or anti-B serum.

Leukocytes: Basophil (description, cells/mm3 of blood, and function)

description - Nucleus lobed; large blue-purple cytoplamsic granules; diameter 10-14 μm.
cells/mm3 of blood - 20-50 differential count <1%
function - release histamine and other mediators of inflammation; contain heparin, and anticoagulant.



hematocrit
the ratio of the volume of red blood cells to the total volume of blood. an instrument for measuring this, typically by centrifugation.
Hemostasis
is a protective mechanism that is set into motion when a blood vessel breaks. During hemostasis, three events occur in the following order: vascular spasm, platelet plug formation, and coagulation (blood clotting).

















































